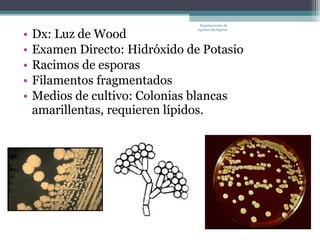
Departamento de


•   Dx: Luz de Wood
                                Agentes Biológicos




•   Examen Directo: Hidróxido de Potasio
•   Racimos de esporas
•   Filamentos fragmentados
•   Medios de cultivo: Colonias blancas
    amarillentas, requieren lípidos.

Este documento resume varios tipos de hongos que causan micosis superficiales en humanos. Describe las características clínicas, patogénicas y de tratamiento de tineas, pitiriasis versicolor, piedra negra y pierda blanca, incluyendo los agentes causales más comunes, las áreas del cuerpo afectadas, signos y síntomas, y tratamientos recomendados. El documento fue escrito por el Departamento de Agentes Biológicos.